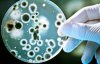

Американские ученые вывели модифицированные соевые бобы. Они будут давать на 50% больший урожай по сравнению с сегодняшним уровнем урожайности.
Это результаты трехлетнего полевого исследования американских ученых из The School of Integrative Biology. Об этом пишут "Факты".
Модифицированная культура дает больше урожая в условиях одновременного воздействия повышенной температуры и повышенного уровня углекислого газа.
Благодаря эксперименту специалисты нашли способ уменьшить потери урожая из-за изменения климата на планете, говорят ученые.
ЧИТАЙТЕ ТАКЖЕ: Как ученым NASA помогут чернобыльские грибы
Британский физик-теоретик Стивен Хокинг рассказал, как выжить людям. Он предупредил, что будущее общества зависит от того, смогут ли люди найти новый дом на другой планете.

Комментарии